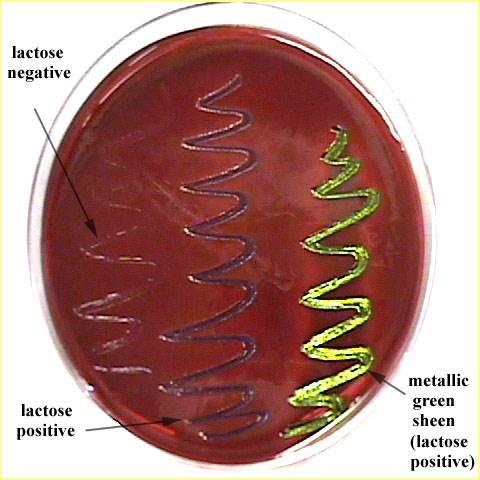

Eosin Methylene Blue Agar
- It contains the dyes eosin and methylene blue, which inhibit the growth of gram-positive bacteria and therefore select for gram-negative bacteria.
- Strong acid production by E. coli precipitates
What kind of streak plate is this?
eosin methylene blue

What kind of streak plate is this?
Casein Agar

Nutrient agar plate?

Right side

Citrate Test

A) (-)
B) (+)

Starch Hydrolysis

Left:(-)
Right: (+)

Casein Hydrolysis

Top: (-)
Bottom: (+)

Gelatin Hydrolysis

A) (+)
B) (-)

Catalase test

A) (-)
B) (+)
What test is this?
Lactose

What test is this?
Glucose

What test has a red top?
INC
Acid Fast Stain Procedure (pg.92)
1. Carbolfuchsin-->Heat fix (5 min)
2. Acid Alcohol (1 min)
3. Methylene Blue (1 min)
Gram Stain Procedure (pg.87)
1. Crystal violet (1 minute)
2. Iodine (1 minute)
3.
Alcohol (1 minute)
4. Safranin (1 minute)
Endospore Stain Procedure (pg.99)
1. Malachite Green over steam (10 min)
2. Water
3.
Safranin (30s)
Nitrate Reduction Test
I N C